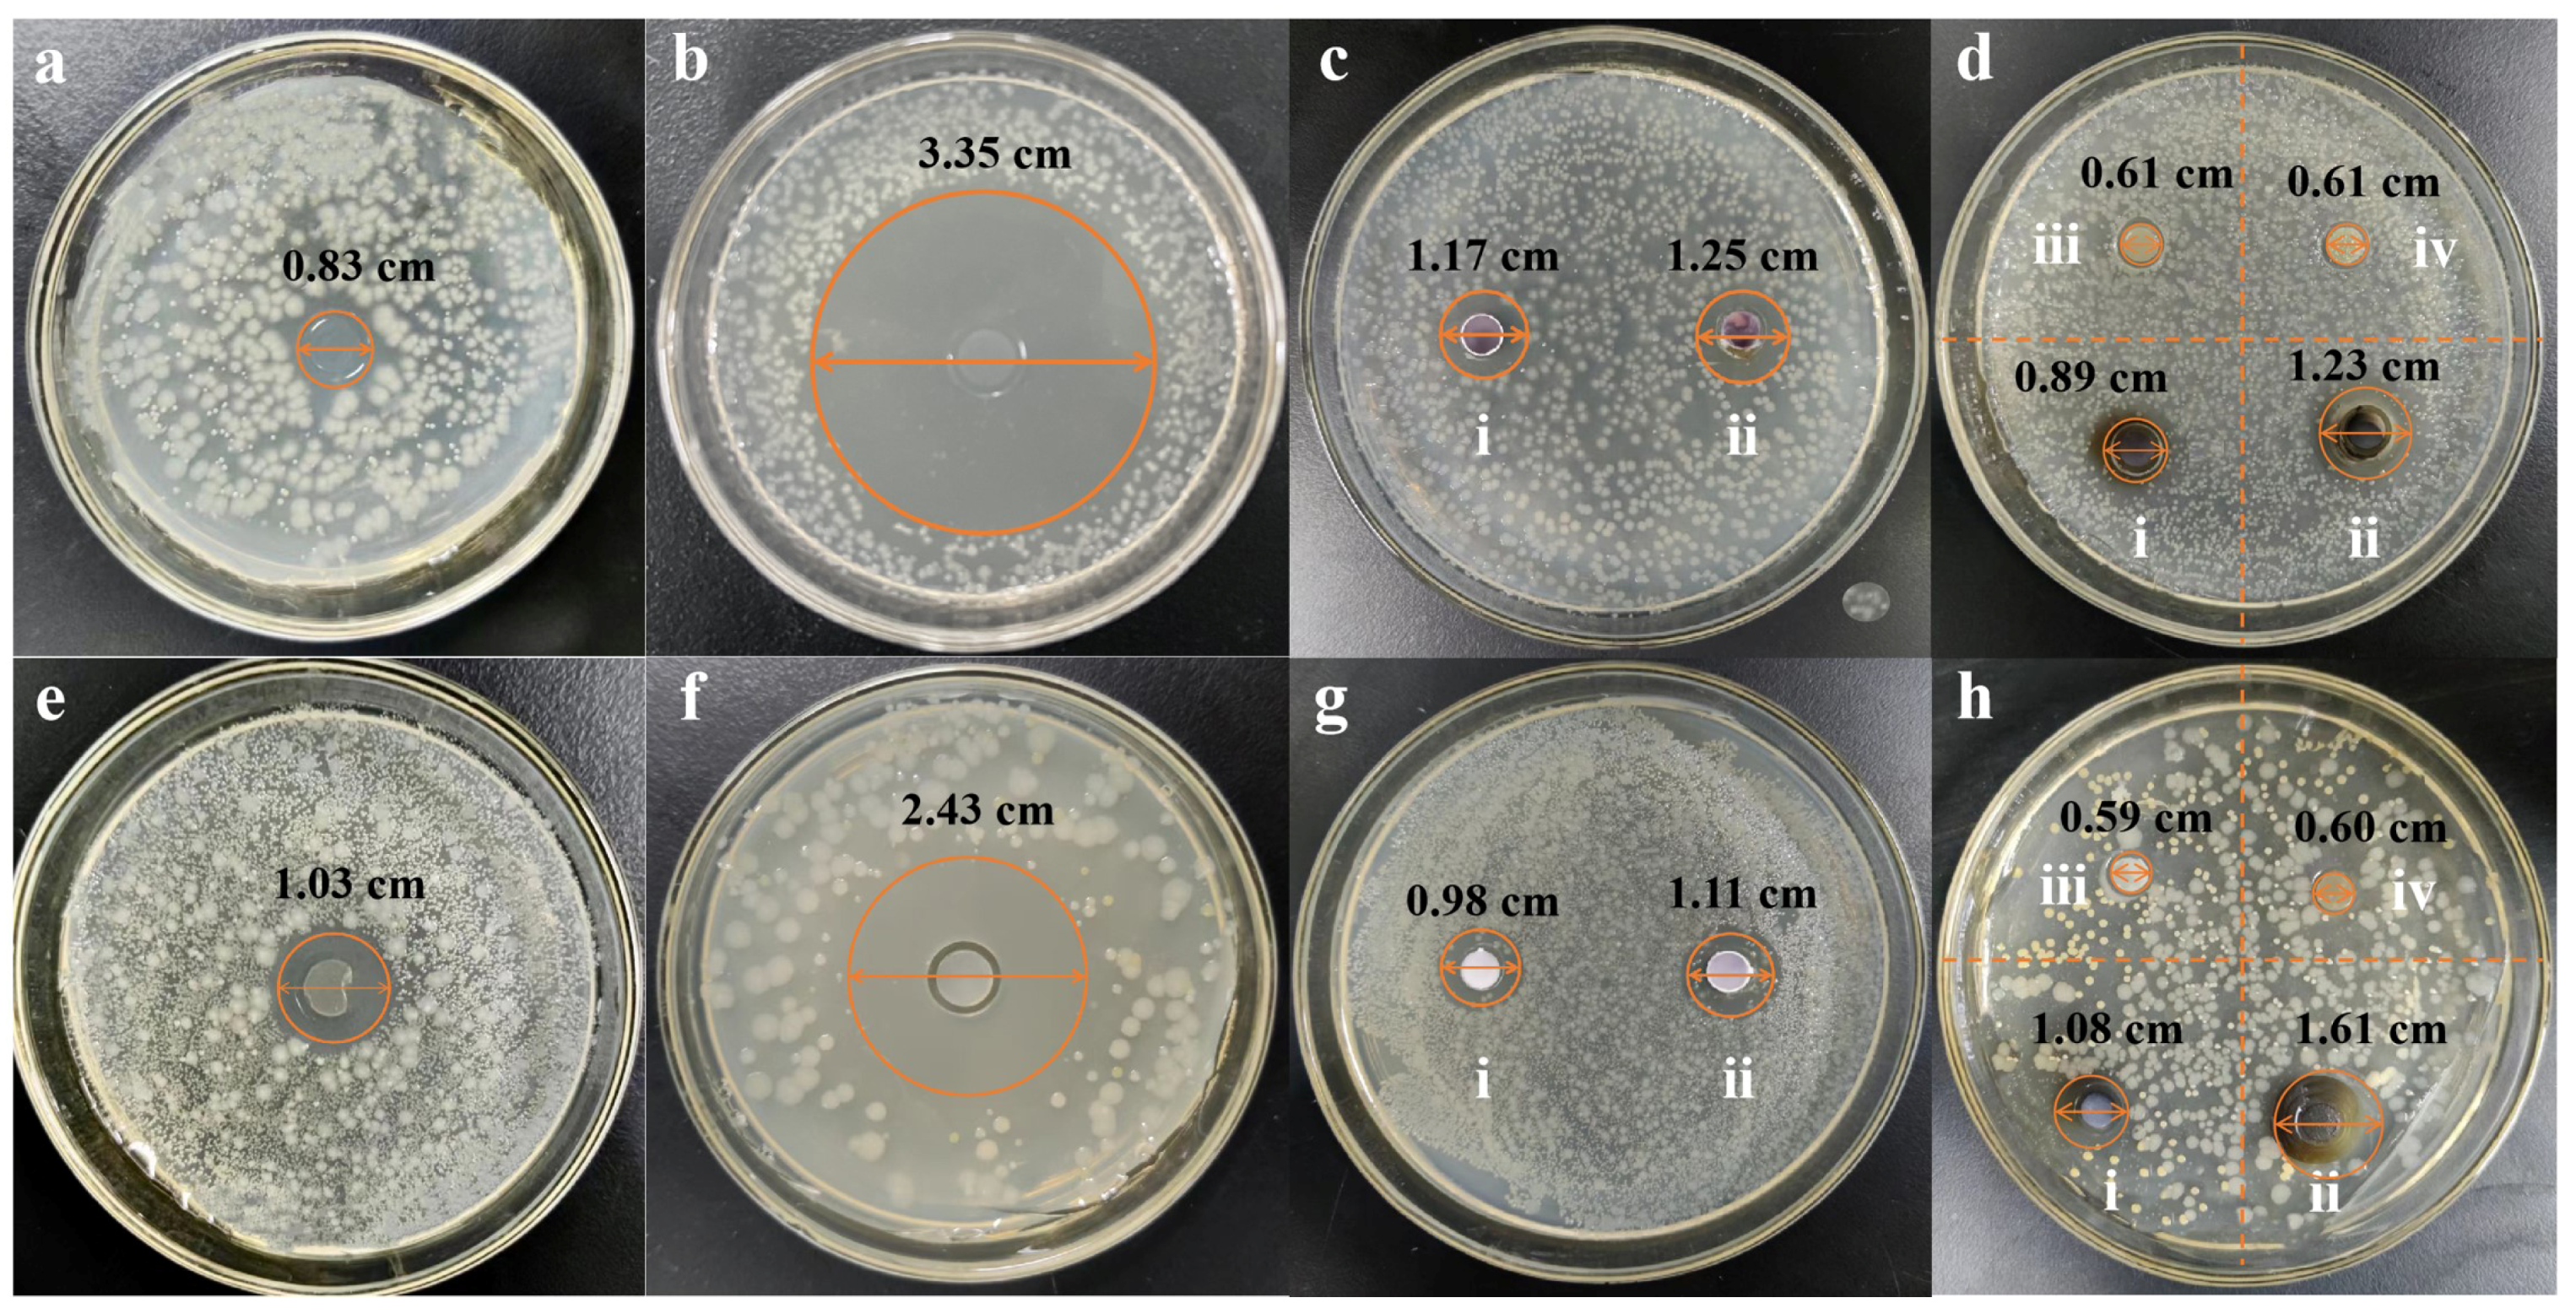
Nanomaterials 15 01064 g004

Zingiber officinale Polysaccharide Silver Nanoparticles: A Study of Its Synthesis, Structure Elucidation, Antibacterial and Immunomodulatory Activities
Abstract
1. Introduction
2. Materials and Methods
2.1. Materials and Reagents
2.2. Preparation of ZOP
2.3. Preparation of Z. officinale Polysaccharide Nanoparticles (ZOP-NPs)
2.4. Preparation of ZOP-NPs-AgNPs
2.4.1. Single-Factor Experiment
2.4.2. Box–Behnken Response Surface Methodology
2.5. Structural Characterization of ZOP-NPs-AgNPs
2.5.1. UV-Vis Spectroscopy Analysis
2.5.2. FT-IR Spectroscopy Analysis
2.5.3. SEM Analysis
2.5.4. TEM Analysis
2.5.5. XRD Analysis
2.5.6. TGA Analysis
2.6. Antibacterial Activity of ZOP-NPs-AgNPs
2.6.1. The Determination of the Diameter of the Bacteriostatic Zone
2.6.2. The Minimum Inhibitory Concentration (MIC) of ZOP-NPs-AgNPs
2.6.3. The Minimum Bactericidal Concentration (MBC) of ZOP-NPs-AgNPs
2.7. Immunomodulatory Activity of ZOP-NPs-AgNPs
2.7.1. Culture of RAW264.7 Cells
2.7.2. Cell Proliferation Experiment
2.7.3. Cell Phagocytosis Experiment
2.7.4. The Effect Test of NO Secretion by Macrophages
2.7.5. Assay of Cytokines
2.7.6. Data and Analysis
3. Results and Discussion
3.1. Preparation of ZOP-NPs-AgNPs
3.1.1. Single-Factor Experiment Analysis
3.1.2. Response Surface Results and Contour Plots
3.2. Structural Characterization of ZOP-NPs-AgNPs
3.2.1. The Determination of the Particle Size and Silver Chelating Rate
3.2.2. UV-Vis Analysis
3.2.3. FT-IR Analysis
3.2.4. TEM Analysis
3.2.5. SEM Analysis
3.2.6. XRD Analysis
3.2.7. TGA Analysis
3.3. Antibacterial Activity of ZOP-NPs-AgNPs
3.3.1. Determination of Diameter of Bacteriostatic Zone
3.3.2. The MIC of ZOP-NPs-AgNPs
3.3.3. The MBC of ZOP-NPs-AgNPs
3.4. Immunomodulatory Activity of ZOP-NPs-AgNPs
3.4.1. Cell Proliferation Activity
3.4.2. Cell Phagocytic Activity
3.4.3. The Effect Test of NO Secretion by Macrophages
3.4.4. The Determination of the Cytokine Secretion Level
4. Conclusions
Author Contributions
Funding
Data Availability Statement
Conflicts of Interest
References
- Waiskopf, N.; Ben-Shahar, Y.; Galchenko, M.; Carmel, I.; Moshitzky, G.; Soreq, H.; Banin, U. Photocatalytic Reactive Oxygen Species Formation by Semiconductor–Metal Hybrid Nanoparticles. Toward Light-Induced Modulation of Biological Processes. Nano Lett. 2016, 16, 4266–4273. [Google Scholar] [CrossRef] [PubMed]
- Wang, X.; Xuan, S.; Ding, K.; Jin, P.; Zheng, Y.; Wu, Z. Photothermal controlled antibacterial Ta4C3Tx-AgNPs/nanocellulose bioplastic food packaging. Food Chem. 2024, 448, 139126. [Google Scholar] [CrossRef] [PubMed]
- Trotta, F.; Da Silva, S.; Massironi, A.; Mirpoor, S.F.; Lignou, S.; Ghawi, S.K.; Charalampopoulos, D. Advancing Food Preservation: Sustainable Green-AgNPs Bionanocomposites in Paper-Starch Flexible Packaging for Prolonged Shelf Life. Polymers 2024, 16, 941. [Google Scholar] [CrossRef] [PubMed]
- Chen, L.-L.; Shi, W.-P.; Zhou, Y.-Q.; Zhang, T.-D.; Lin, W.-J.; Guo, W.-H.; Zhou, R.-B.; Yin, D.-C. High-efficiency antibacterial calcium alginate/lysozyme/AgNPs composite sponge for wound healing. Int. J. Biol. Macromol. 2023, 256, 128370. [Google Scholar] [CrossRef]
- González-Aguiñaga, E.; Cardoso-Ávila, P.E.; Patakfalvi, R.; Pedro-Garcia, F. The morphology-dependent catalytic activity of anisotropic silver nanoparticles. Mater. Lett. 2023, 342, 134334. [Google Scholar] [CrossRef]
- Slepička, P.; Kasálková, N.S.; Siegel, J.; Kolská, Z.; Švorčík, V. Methods of Gold and Silver Nanoparticles Preparation. Materials 2019, 13, 1. [Google Scholar] [CrossRef]
- Koesmawati, T.A.; Febrianti, F.; Halim, R.; Fitria, N.; Tanuwidjaja, S.; Rohman, O.; Syamsudin, A. Mercury Determination in Fish Using Cold Vapour-Atomic Absorption Spectrometry (CV-AAS) with Sodium Borohydride (NaBH4) as the Reductor. IOP Conf. Ser. Earth Environ. Sci. 2023, 1201, 012026. [Google Scholar] [CrossRef]
- Sawant, P.; Chopade, S.; Shrotriya, S.; Patil, M.; Mulgund, S. Controlled Size Silver Nanoparticles Stabilised with Trisodium Citrate as Carriers for Econazole Nitrate: Synthesis, Characterization and Antifungal Activity. BioNanoScience 2025, 15, 265. [Google Scholar] [CrossRef]
- Khan, Z.; Al-Thabaiti, S.A.; Obaid, A.Y.; Al-Youbi, A. Preparation and characterization of silver nanoparticles by chemical reduction method. Colloids Surf. B Biointerfaces 2011, 82, 513–517. [Google Scholar] [CrossRef]
- Bedlovicova, Z.; Strapac, I.; Balaz, M.; Salayova, A. A Brief Overview on Antioxidant Activity Determination of Silver Nanoparticles. Molecules 2020, 25, 3191. [Google Scholar] [CrossRef]
- Rolim, W.R.; Pelegrino, M.T.; Lima, B.d.A.; Ferraz, L.S.; Costa, F.N.; Bernardes, J.S.; Rodigues, T.; Brocchi, M.; Seabra, A.B. Green tea extract mediated biogenic synthesis of silver nanoparticles: Characterization, cytotoxicity evaluation and antibacterial activity. Appl. Surf. Sci. 2019, 463, 66–74. [Google Scholar] [CrossRef]
- Venkatpurwar, V.; Pokharkar, V. Green synthesis of silver nanoparticles using marine polysaccharide: Study of in-vitro antibacterial activity. Mater. Lett. 2011, 65, 999–1002. [Google Scholar] [CrossRef]
- Mohammed, A.N. Resistance of bacterial pathogens to calcium hypochlorite disinfectant and evaluation of the usability of treated filter paper impregnated with nanosilver composite for drinking water purification. J. Glob. Antimicrob. Resist. 2019, 16, 28–35. [Google Scholar] [CrossRef] [PubMed]
- Rai, M.; Yadav, A.; Gade, A. Silver nanoparticles as a new generation of antimicrobials. Biotechnol. Adv. 2009, 27, 76–83. [Google Scholar] [CrossRef]
- Yu, N.; Wang, X.; Ning, F.; Jiang, C.; Li, Y.; Peng, H.; Xiong, H. Development of antibacterial pectin from Akebia trifoliata var. australis waste for accelerated wound healing. Carbohydr. Polym. 2019, 217, 58–68. [Google Scholar] [CrossRef]
- Senthilkumar, P.; Yaswant, G.; Kavitha, S.; Chandramohan, E.; Kowsalya, G.; Vijay, R.; Sudhagar, B.; Kumar, D.R.S. Preparation and characterization of hybrid chitosan-silver nanoparticles (Chi-Ag NPs); A potential antibacterial agent. Int. J. Biol. Macromol. 2019, 141, 290–298. [Google Scholar] [CrossRef]
- Ma, L.; Jiang, W.; Xun, X.; Liu, M.; Han, X.; Xie, J.; Wang, M.; Zhang, Q.; Peng, Z.; Ao, H. Homogeneous silver nanoparticle loaded polydopamine/polyethyleneimine-coated bacterial cellulose nanofibers for wound dressing. Int. J. Biol. Macromol. 2023, 246, 125658. [Google Scholar] [CrossRef]
- Meng, Y.; Zhang, H.; Hu, N.; Zhang, B.; Qiu, Z.; Hu, J.; Zheng, G.; Zhang, L.; Xu, X. Construction of silver nanoparticles by the triple helical polysaccharide from black fungus and the antibacterial activities. Int. J. Biol. Macromol. 2021, 182, 1170–1178. [Google Scholar] [CrossRef]
- Martínez-Rodríguez, M.d.L.Á.; Madla-Cruz, E.; Urrutia-Baca, V.H.; de la Garza-Ramos, M.A.; González-González, V.A.; Garza-Navarro, M.A. Influence of Polysaccharides’ Molecular Structure on the Antibacterial Activity and Cytotoxicity of Green Synthesized Composites Based on Silver Nanoparticles and Carboxymethyl-Cellulose. Nanomaterials 2020, 10, 1164. [Google Scholar] [CrossRef]
- Ji, X.; Hou, C.; Shi, M.; Yan, Y.; Liu, Y. An Insight into the Research Concerning Panax ginseng C.A. Meyer Polysaccharides: A Review. Food Rev. Int. 2020, 38, 1–17. [Google Scholar] [CrossRef]
- Hsiang, C.-Y.; Cheng, H.-M.; Lo, H.-Y.; Li, C.-C.; Chou, P.-C.; Lee, Y.-C.; Ho, T.-Y. Ginger and Zingerone Ameliorate Lipopolysaccharide-Induced Acute Systemic Inflammation in Mice, Assessed by Nuclear Factor-κB Bioluminescent Imaging. J. Agric. Food Chem. 2015, 63, 6051–6058. [Google Scholar] [CrossRef] [PubMed]
- Shanmugam, K.R.; Mallikarjuna, K.; Kesireddy, N.; Reddy, K.S. Neuroprotective effect of ginger on anti-oxidant enzymes in streptozotocin-induced diabetic rats. Food Chem. Toxicol. 2011, 49, 893–897. [Google Scholar] [CrossRef] [PubMed]
- Chen, G.-T.; Yuan, B.; Wang, H.-X.; Qi, G.-H.; Cheng, S.-J. Characterization and antioxidant activity of polysaccharides obtained from ginger pomace using two different extraction processes. Int. J. Biol. Macromol. 2019, 139, 801–809. [Google Scholar] [CrossRef] [PubMed]
- Yang, X.; Wei, S.; Lu, X.; Qiao, X.; Simal-Gandara, J.; Capanoglu, E.; Woźniak, Ł.; Zou, L.; Cao, H.; Xiao, J.; et al. A neutral polysaccharide with a triple helix structure from ginger: Characterization and immunomodulatory activity. Food Chem. 2021, 350, 129261. [Google Scholar] [CrossRef]
- Chen, X.; Chen, G.; Wang, Z.; Kan, J. A comparison of a polysaccharide extracted from ginger (Zingiber officinale) stems and leaves using different methods: Preparation, structure characteristics, and biological activities. Int. J. Biol. Macromol. 2020, 151, 635–649. [Google Scholar] [CrossRef]
- Jing, Y.; Cheng, W.; Ma, Y.; Zhang, Y.; Li, M.; Zheng, Y.; Zhang, D.; Wu, L. Structural Characterization, Antioxidant and Antibacterial Activities of a Novel Polysaccharide from Zingiber officinale and Its Application in Synthesis of Silver Nanoparticles. Front. Nutr. 2022, 9, 917094. [Google Scholar] [CrossRef]
- Wang, L.; Zhang, Y. Heat-induced self-assembly of zein nanoparticles: Fabrication, stabilization and potential application as oral drug delivery. Food Hydrocoll. 2019, 90, 403–412. [Google Scholar] [CrossRef]
- Rangaraju, M.; Abewaa, M.; Hailemariam, E.; Abay, Y.; Prabhu, S.V.; Abdu, J.; Mengistu, A. Bacterial growth inhibition in spring water utilizing silver nanoparticles: Optimization using central composite design. Results Eng. 2024, 23, 102562. [Google Scholar] [CrossRef]
- Ghetas, H.A.; Abdel-Razek, N.; Shakweer, M.S.; Abotaleb, M.M.; Paray, B.A.; Ali, S.; Eldessouki, E.A.; Dawood, M.A.; Khalil, R.H. Antimicrobial activity of chemically and biologically synthesized silver nanoparticles against some fish pathogens. Saudi J. Biol. Sci. 2021, 29, 1298–1305. [Google Scholar] [CrossRef]
- Lian, Y.; Ma, N.; Cheng, Q.; Luo, M.; Xu, Z.; He, F.; Zhou, X.; Zhang, Y.; Jin, D.; Kong, Y.; et al. Fabrication of Nano-Silver Composite Using Amomum longiligulare Fruit Polysaccharides and Their Biological Activities. Int. J. Nanomed. 2025, 20, 1881–1898. [Google Scholar] [CrossRef]
- Shetta, A.; Kegere, J.; Mamdouh, W. Comparative study of encapsulated peppermint and green tea essential oils in chitosan nanoparticles: Encapsulation, thermal stability, in-vitro release, antioxidant and antibacterial activities. Int. J. Biol. Macromol. 2019, 126, 731–742. [Google Scholar] [CrossRef] [PubMed]
- Sun, S.; Huang, S.; Shi, Y.; Shao, Y.; Qiu, J.; Yan, Z.; Ding, L.; Zou, D.; Xin, Z. Extraction, isolation, characterization and an-timicrobial activities of non-extractable polyphenols from pomegranate peel. Food Chem. 2021, 351, 129232. [Google Scholar] [CrossRef] [PubMed]
- Leng, M.; Jiang, H.; Zhang, S.; Bao, Y. Green Synthesis of Gold Nanoparticles from Polygahatous Polysaccharides and Their Anticancer Effect on Hepatic Carcinoma through Immunoregulation. ACS Omega 2024, 9, 21144–21151. [Google Scholar] [CrossRef] [PubMed]
- Hu, Z.; Zhou, H.; Li, Y.; Wu, M.; Yu, M.; Sun, X. Optimized purification process of polysaccharides from Carex meyeriana Kunth by macroporous resin, its characterization and immunomodulatory activity. Int. J. Biol. Macromol. 2019, 132, 76–86. [Google Scholar] [CrossRef]
- Roszczyk, A.; Turło, J.; Zagożdżon, R.; Kaleta, B. Immunomodulatory Properties of Polysaccharides from Lentinula edodes. Int. J. Mol. Sci. 2022, 23, 8980. [Google Scholar] [CrossRef]
- Cao, X.L.; Cheng, C.; Ma, Y.L.; Zhao, C.S. Preparation of silver nanoparticles with antimicrobial activities and the researches of their biocompatibilities. J. Mater. Sci. Mater. Med. 2010, 21, 2861–2868. [Google Scholar] [CrossRef]
- Abdel-Mohsen, A.; Abdel-Rahman, R.M.; Hrdina, R.; Imramovský, A.; Burgert, L.; Aly, A. Antibacterial cotton fabrics treated with core–shell nanoparticles. Int. J. Biol. Macromol. 2012, 50, 1245–1253. [Google Scholar] [CrossRef]
- Abdel-Mohsen, A.; Abdel-Rahman, R.M.; Fouda, M.M.; Vojtova, L.; Uhrova, L.; Hassan, A.; Al-Deyab, S.S.; El-Shamy, I.E.; Jancar, J. Preparation, characterization and cytotoxicity of schizophyllan/silver nanoparticle composite. Carbohydr. Polym. 2014, 102, 238–245. [Google Scholar] [CrossRef]
- Yang, N.; Li, W.-H. Mango peel extract mediated novel route for synthesis of silver nanoparticles and antibacterial application of silver nanoparticles loaded onto non-woven fabrics. Ind. Crop. Prod. 2013, 48, 81–88. [Google Scholar] [CrossRef]
- Wang, G.; Yang, X.; Chen, X.; Huang, J.; He, R.; Zhang, R.; Zhang, Y. Construction and antibacterial activities of walnut green husk polysaccharide based silver nanoparticles (AgNPs). Int. J. Biol. Macromol. 2024, 276, 133798. [Google Scholar] [CrossRef]
- Zhu, Y.; Pang, X.; Zhang, W.; Zhang, C.; Zhang, B.; Fu, J.; Zhao, H.; Han, W. Green synthesis of silver nanoparticles using persimmon polysaccharides for enhanced polysaccharide-based film performance. Food Res. Int. 2025, 209, 116252. [Google Scholar] [CrossRef] [PubMed]
- Taher, M.A.; Khojah, E.; Darwish, M.S.; Elsherbiny, E.A.; Elawady, A.A.; Dawood, D.H. Biosynthesis of Silver Nanoparticles by Polysaccharide of Leucaena leucocephala Seeds and Their Anticancer, Antifungal Properties and as Preservative of Composite Milk Sample. J. Nanomater. 2022, 2022, 7490221. [Google Scholar] [CrossRef]
- Chen, Y.; Sun, W.; Qu, D.; Ma, Y.; Liu, C.; Zhou, J. Enhanced stability and antibacterial efficacy of a traditional Chinese medicine-mediated silver nanoparticle delivery system. Int. J. Nanomed. 2014, 9, 5491–5502. [Google Scholar] [CrossRef] [PubMed]
- Devasvaran, K.; Alallam, B.; Lee, C.; Yong, Y.K.; Lim, V. Clinacanthus nutans crude polysaccharide extract as a green platform for microwave-assisted synthesis of silver nanoparticles: Optimization, characterization, and evaluation of bioactivities. Int. J. Biol. Macromol. 2024, 278, 134893. [Google Scholar] [CrossRef]
- Wang, L.; Tian, Y.; Zhang, P.; Li, C.; Chen, J. Polysaccharide isolated from Rosa roxburghii Tratt fruit as a stabilizing and reducing agent for the synthesis of silver nanoparticles: Antibacterial and preservative properties. J. Food Meas. Charact. 2022, 16, 1241–1251. [Google Scholar] [CrossRef]
- Cai, Z.; Dai, Q.; Guo, Y.; Wei, Y.; Wu, M.; Zhang, H. Glycyrrhiza polysaccharide-mediated synthesis of silver nanoparticles and their use for the preparation of nanocomposite curdlan antibacterial film. Int. J. Biol. Macromol. 2019, 141, 422–430. [Google Scholar] [CrossRef]
- Ma, Z.; Liu, J.; Liu, Y.; Zheng, X.; Tang, K. Green synthesis of silver nanoparticles using soluble soybean polysaccharide and their application in antibacterial coatings. Int. J. Biol. Macromol. 2021, 166, 567–577. [Google Scholar] [CrossRef]
- Wang, L.; Zhang, T.; Li, P.; Huang, W.; Tang, J.; Wang, P.; Liu, J.; Yuan, Q.; Bai, R.; Li, B.; et al. Use of Synchrotron Radiation-Analytical Techniques To Reveal Chemical Origin of Silver-Nanoparticle Cytotoxicity. ACS Nano 2015, 9, 6532–6547. [Google Scholar] [CrossRef]
- Jian, W.; Ma, Y.; Wu, H.; Zhu, X.; Wang, J.; Xiong, H.; Lin, L.; Wu, L. Fabrication of highly stable silver nanoparticles using polysaccharide-protein complexes from abalone viscera and antibacterial activity evaluation. Int. J. Biol. Macromol. 2019, 128, 839–847. [Google Scholar] [CrossRef]
- Mehwish, H.M.; Liu, G.; Rajoka, M.S.R.; Cai, H.; Zhong, J.; Song, X.; Xia, L.; Wang, M.; Aadil, R.M.; Inam-Ur-Raheem, M.; et al. Therapeutic potential of Moringa oleifera seed polysaccharide embedded silver nanoparticles in wound healing. Int. J. Biol. Macromol. 2021, 184, 144–158. [Google Scholar] [CrossRef]
- Skiba, M.I.; Vorobyova, V.I.; Pivovarov, A.; Makarshenko, N.P. Green Synthesis of Silver Nanoparticles in the Presence of Polysaccharide: Optimization and Characterization. J. Nanomater. 2020, 2020, 3051308. [Google Scholar] [CrossRef]
- Hamida, R.S.; Abdelmeguid, N.E.; Ali, M.A.; Bin-Meferij, M.; Khalil, M.I. Synthesis of Silver Nanoparticles Using a Novel Cyanobacteria Desertifilum sp. extract: Their Antibacterial and Cytotoxicity Effects. Int. J. Nanomed. 2020, 15, 49–63. [Google Scholar] [CrossRef] [PubMed]
- Ankamwar, B.; Damle, C.; Ahmad, A.; Sastry, M. Biosynthesis of Gold and Silver Nanoparticles Using Emblica Officinalis Fruit Extract, Their Phase Transfer and Transmetallation in an Organic Solution. J. Nanosci. Nanotechnol. 2005, 5, 1665–1671. [Google Scholar] [CrossRef] [PubMed]
- Padinjarathil, H.; Joseph, M.M.; Unnikrishnan, B.; Preethi, G.; Shiji, R.; Archana, M.; Maya, S.; Syama, H.; Sreelekha, T. Galactomannan endowed biogenic silver nanoparticles exposed enhanced cancer cytotoxicity with excellent biocompatibility. Int. J. Biol. Macromol. 2018, 118, 1174–1182. [Google Scholar] [CrossRef]
- Wei, Z.; Wei, X.; Juan, L.; Huang, L.; Li, Y.; Luo, Y.; Huang, L.; Jin, W. Comparative catalytic and bacteriostatic properties of silver nanoparticles biosynthesized using three kinds of polysaccharide. AIP Adv. 2018, 8, 065222. [Google Scholar]
- Sondi, I.; Salopek-Sondi, B. Silver nanoparticles as antimicrobial agent: A case study on E. coli as a model for Gram-negative bacteria. J. Colloid Interface Sci. 2004, 275, 177–182. [Google Scholar] [CrossRef]
- Affes, S.; Maalej, H.; Aranaz, I.; Kchaou, H.; Acosta, N.; Heras, Á.; Nasri, M. Controlled size green synthesis of bioactive silver nanoparticles assisted by chitosan and its derivatives and their application in biofilm preparation. Carbohydr. Polym. 2020, 236, 116063. [Google Scholar] [CrossRef]
- He, Y.; Li, H.; Fei, X.; Peng, L. Carboxymethyl cellulose/cellulose nanocrystals immobilized silver nanoparticles as an effective coating to improve barrier and antibacterial properties of paper for food packaging applications. Carbohydr. Polym. 2021, 252, 117156. [Google Scholar] [CrossRef]
- Liu, X.; Zhang, X.; Zhang, X.; Li, F.; Tian, Y.; Du, M.; Zhao, H.; Shao, L.; Tian, Q. Antibacterial activity of Osmunda japonica (Thunb) polysaccharides and its effect on tomato quality maintenance during storage. Int. J. Food Sci. Technol. 2020, 55, 2851–2862. [Google Scholar] [CrossRef]
- Chung, Y.-C.; Su, Y.-P.; Chen, C.-C.; Jia, G.; Wang, H.-L.; Wu, J.C.G.; Lin, J.-G. Relationship between antibacterial activity of chitosan and surface characteristics of cell wall. Acta Pharmacol. Sin. 2004, 25, 932–936. [Google Scholar]
- Jiji, S.; Udhayakumar, S.; Maharajan, K.; Rose, C.; Muralidharan, C.; Kadirvelu, K. Bacterial cellulose matrix with in situ impregnation of silver nanoparticles via catecholic redox chemistry for third degree burn wound healing. Carbohydr. Polym. 2020, 245, 116573. [Google Scholar] [CrossRef] [PubMed]
- Güneş, Ç.C.; Dündar, M.A.; Demirel, K.M.; Avcı, A. Enhancement of PCL/PLA Electrospun Nanocomposite Fibers Comprising Silver Nanoparticles Encapsulated with Thymus Vulgaris L. Molecules for Antibacterial and Anticancer Activities. ACS Biomater. Sci. Eng. 2022, 8, 3717–3732. [Google Scholar] [CrossRef] [PubMed]
- El-Naggar, N.E.-A.; Hussein, M.H.; Shaaban-Dessuuki, S.A.; Dalal, S.R. Production, extraction and characterization of Chlorella vulgaris soluble polysaccharides and their applications in AgNPs biosynthesis and biostimulation of plant growth. Sci. Rep. 2020, 10, 3011. [Google Scholar] [CrossRef] [PubMed]
- Fang, Y.; Hong, C.; Chen, F.; Gui, F.; You, Y.; Guan, X.; Pan, X. Green synthesis of nano silver by tea extract with high anti-microbial activity. Inorg. Chem. Commun. 2021, 132, 108808. [Google Scholar] [CrossRef]
- Durán, N.; Durán, M.; de Jesus, M.B.; Seabra, A.B.; Fávaro, W.J.; Nakazato, G. Silver nanoparticles: A new view on mechanistic aspects on antimicrobial activity. Nanomedicine 2016, 12, 789–799. [Google Scholar] [CrossRef]
- Gopinath, K.; Gowri, S.; Arumugam, A. Phytosynthesis of silver nanoparticles using Pterocarpus santalinus leaf extract and their antibacterial properties. J. Nanostruct. Chem. 2013, 3, 68. [Google Scholar] [CrossRef]
- Islam, S.U.; Butola, B.; Kumar, A. Green chemistry based in-situ synthesis of silver nanoparticles for multifunctional finishing of chitosan polysaccharide modified cellulosic textile substrate. Int. J. Biol. Macromol. 2020, 152, 1135–1145. [Google Scholar] [CrossRef]
- Chernikov, O.V.; Chiu, H.-W.; Li, L.-H.; Kokoulin, M.S.; Molchanova, V.I.; Hsu, H.-T.; Ho, C.-L.; Hua, K.-F. Immunomodulatory Properties of Polysaccharides from the Coral Pseudopterogorgia americana in Macrophages. Cells 2021, 10, 3531. [Google Scholar] [CrossRef]
- Yang, H.; Jiang, C.; Chen, X.; He, K.; Hu, Y. Protective effects of sinomenine against LPS-induced inflammation in piglets. Microb. Pathog. 2017, 110, 573–577. [Google Scholar] [CrossRef]
- Jing, Y.; Zhang, Y.; Li, P.; Zhang, H.; Cheng, W.; Zhang, Y.; Zheng, Y.; Wu, L.; Zhang, D. Optimization of technology, structural characterization, derivatization, antioxidant and immunomodulatory activities of Salvia miltiorrhiza polysaccharides. J. Food Meas. Charact. 2022, 16, 1754–1767. [Google Scholar] [CrossRef]
- Ren, D.; Lin, D.; Alim, A.; Zheng, Q.; Yang, X. Chemical characterization of a novel polysaccharide ASKP-1 from Artemisia sphaerocephala Krasch seed and its macrophage activation via MAPK, PI3k/Akt and NF-κB signaling pathways in RAW264.7 cells. Food Funct. 2017, 8, 1299–1312. [Google Scholar] [CrossRef] [PubMed]
- Ahmed, S.; Mohamed, H.T.; El-Husseiny, N.; Mahdy, M.M.E.; Safwat, G.; Diab, A.A.; El-Sherif, A.A.; El-Shinawi, M.; Mo-hamed, M.M. IL-8 secreted by tumor associated macrophages contribute to lapatinib resistance in HER2-positive locally ad-vanced breast cancer via activation of Src/STAT3/ERK1/2-mediated EGFR signaling. Biochim. Biophys. Acta Mol. Cell Res. 2021, 1868, 118995. [Google Scholar] [CrossRef] [PubMed]
- Mohamed, A.; Dayo, M.; Alahmadi, S.; Ali, S. Anti-Inflammatory and Antimicrobial Activity of Silver Nanoparticles Green-Synthesized Using Extracts of Different Plants. Nanomaterials 2024, 14, 1383. [Google Scholar] [CrossRef] [PubMed]

| Variables | Level | ||
|---|---|---|---|
| −1 | 0 | 1 | |
| A: V(AgNO3):V(polysaccharide) | 2.5:1 | 3:1 | 3.5:1 |
| B: Extraction temperature (°C) | 50 | 60 | 70 |
| C: Extraction time (min) | 2 | 3 | 4 |
| Run Numbers | V (AgNO3): V (Polysaccharide) (A) | Extraction Temperature (B) (°C) | Extraction Time (C) (min) | Chelate Rate (%) |
|---|---|---|---|---|
| 1 | −1 | −1 | 0 | 88.51 |
| 2 | 1 | −1 | 0 | 89.01 |
| 3 | −1 | 1 | 0 | 88.97 |
| 4 | 1 | 1 | 0 | 87.83 |
| 5 | −1 | 0 | 0 | 88.63 |
| 6 | 1 | 0 | 0 | 87.98 |
| 7 | −1 | 0 | 1 | 88.61 |
| 8 | 1 | 0 | 1 | 88.85 |
| 9 | 0 | −1 | −1 | 89.63 |
| 10 | 0 | 1 | −1 | 90.47 |
| 11 | 0 | −1 | 1 | 90.52 |
| 12 | 0 | 1 | 1 | 89.79 |
| 13 | 0 | 0 | 0 | 92.79 |
| 14 | 0 | 0 | 0 | 92.92 |
| 15 | 0 | 0 | 0 | 92.33 |
| 16 | 0 | 0 | 0 | 92.25 |
| 17 | 0 | 0 | 0 | 92.25 |
| Source | Sum of Squares | Df | Mean Square | F-Value | p-Value | Significant Level |
|---|---|---|---|---|---|---|
| Model | 48.07 | 9 | 5.34 | 63.31 | <0.0001 | Significant |
| A | 0.53 | 1 | 0.53 | 6.23 | 0.0413 | |
| B | 0.047 | 1 | 0.047 | 0.55 | 0.4819 | |
| C | 0.00045 | 1 | 0.0045 | 0.005334 | 0.9438 | |
| AB | 0.67 | 1 | 0.67 | 7.97 | 0.0257 | |
| AC | 0.89 | 1 | 0.89 | 10.59 | 0.014 | |
| BC | 0.62 | 1 | 0.62 | 7.3 | 0.0305 | |
| A2 | 29.16 | 1 | 29.16 | 345.63 | <0.0001 | |
| B2 | 7.08 | 1 | 7.08 | 83.9 | <0.0001 | |
| C2 | 5.18 | 1 | 5.18 | 61.39 | <0.0001 | |
| Residual | 0.59 | 7 | 0.084 | |||
| Lack of Fit | 0.18 | 3 | 0.059 | 0.57 | 0.6649 | Not significant |
| Pure Error | 0.41 | 4 | 0.1 | |||
| Correlation Total | 48.66 | 16 |
Disclaimer/Publisher’s Note: The statements, opinions and data contained in all publications are solely those of the individual author(s) and contributor(s) and not of MDPI and/or the editor(s). MDPI and/or the editor(s) disclaim responsibility for any injury to people or property resulting from any ideas, methods, instructions or products referred to in the content. |
© 2025 by the authors. Licensee MDPI, Basel, Switzerland. This article is an open access article distributed under the terms and conditions of the Creative Commons Attribution (CC BY) license (https://creativecommons.org/licenses/by/4.0/).
Share and Cite
Chang, X.; Xiao, H.; Li, M.; Jing, Y.; Zheng, K.; Hu, B.; Zheng, Y.; Wu, L. Zingiber officinale Polysaccharide Silver Nanoparticles: A Study of Its Synthesis, Structure Elucidation, Antibacterial and Immunomodulatory Activities. Nanomaterials 2025, 15, 1064. https://doi.org/10.3390/nano15141064
Chang X, Xiao H, Li M, Jing Y, Zheng K, Hu B, Zheng Y, Wu L. Zingiber officinale Polysaccharide Silver Nanoparticles: A Study of Its Synthesis, Structure Elucidation, Antibacterial and Immunomodulatory Activities. Nanomaterials. 2025; 15(14):1064. https://doi.org/10.3390/nano15141064
Chicago/Turabian StyleChang, Xiaoyu, Huina Xiao, Mingsong Li, Yongshuai Jing, Kaiyan Zheng, Beibei Hu, Yuguang Zheng, and Lanfang Wu. 2025. "Zingiber officinale Polysaccharide Silver Nanoparticles: A Study of Its Synthesis, Structure Elucidation, Antibacterial and Immunomodulatory Activities" Nanomaterials 15, no. 14: 1064. https://doi.org/10.3390/nano15141064
APA StyleChang, X., Xiao, H., Li, M., Jing, Y., Zheng, K., Hu, B., Zheng, Y., & Wu, L. (2025). Zingiber officinale Polysaccharide Silver Nanoparticles: A Study of Its Synthesis, Structure Elucidation, Antibacterial and Immunomodulatory Activities. Nanomaterials, 15(14), 1064. https://doi.org/10.3390/nano15141064

